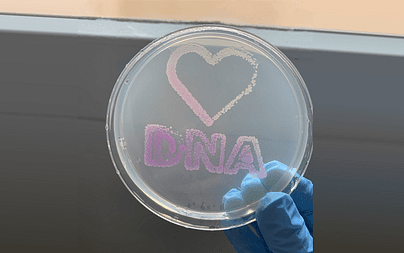
3D Printing Bacteria, It Smells! 🦠

Hi, I am Uri Shaked!
I make stuff, write and speak.
Currently working on Wokwi, also Tiny Tapeout.
Projects
Wokwi
Online Embedded Systems & IoT Simulator (Arduino, ESP32, STM32, etc.)
Tiny Tapeout
An affordable way to manufacture a custom ASIC with your own digital design

The Skull
A spooky, mind-bending Hardware CTF Challenge
The Salsa Beat Machine 🎼
Virtual Salsa band where you are in control. Perfect practice tool for musicians and dancers who want to train their ears!
Good Arduino Code
A curated collection of Arduino coding examples
Hard Drive Xylophone
A bunch of old hard drives play music on water-filled beer bottles